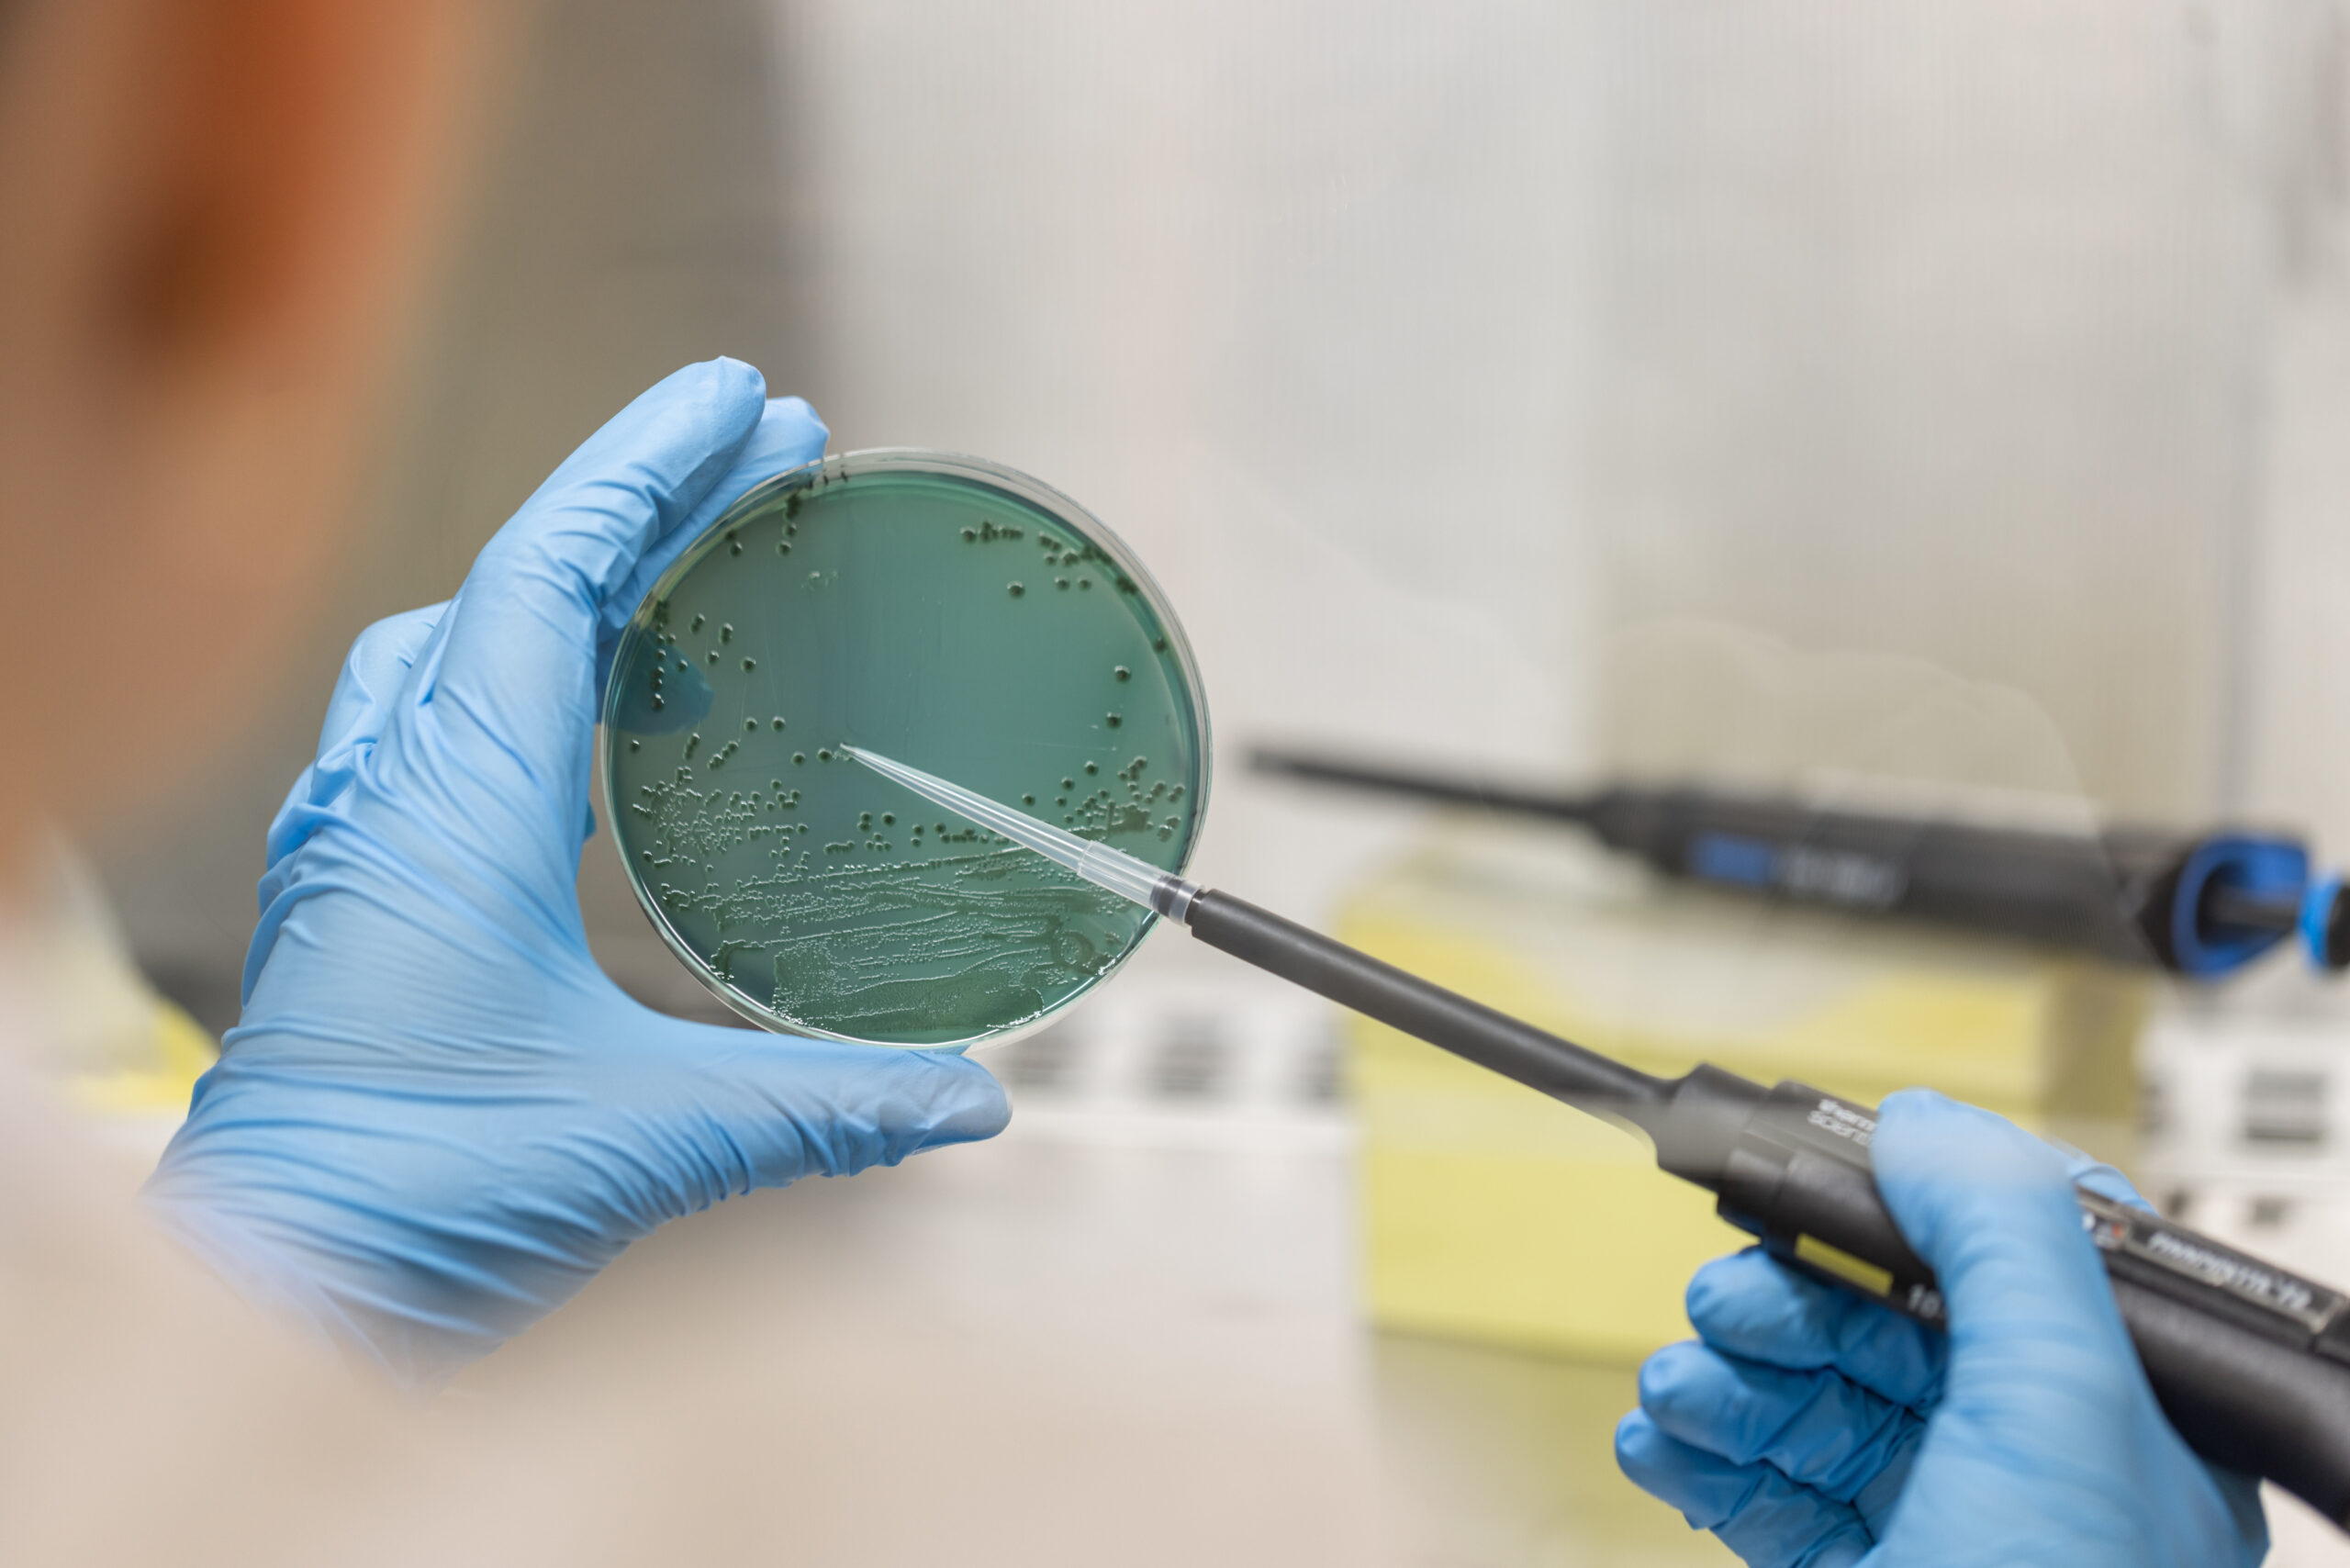

Actualidad que conecta investigación y sociedad
Últimas noticias
La cobertura informativa de Agrotecnio destaca los principales avances e hitos del centro. Da visibilidad a la actividad investigadora, la participación en proyectos y los premios obtenidos por los grupos de investigación, tanto a nivel nacional como internacional.
Con una perspectiva comprometida con la sociedad y el territorio, las noticias también destacan los impactos concretos generados por la investigación del centro, desde la transferencia de conocimiento hasta la respuesta a los retos globales del sistema alimentario.

03/10/2025
Comienza el ‘Agrotecnio Seminar Series’, un ciclo para promover el entendimiento mutuo entre grupos de investigación
Leer la noticia

19/09/2025
Agrotecnio reivindica el trabajo colectivo en la III edición de su Teambuilding
Leer la noticia

10/09/2025
Los bosques de pino carrasco muestran una buena recuperación tras el incendio de la Ribera d’Ebre de 2019
Leer la noticia
08/09/2025
Un estudio alerta de los riesgos de contaminación cruzada durante la elaboración de zumos sin pasteurizar
Leer la noticia

31/07/2025
La UdL y Agrotecnio cierran sus instalaciones al público del 4 al 24 de agosto
Leer la noticia

28/07/2025
Higiene, aislamiento y manipulación adecuada, esenciales para prevenir la transmisión del síndrome reproductivo y respiratorio porcino
Leer la noticia

22/07/2025
El GRAP lidera la innovación en agricultura de precisión en la 15ª Conferencia Europea de Agricultura de Precisión
Leer la noticia

16/07/2025
Agrotecnio y el IRTA impulsan tres proyectos de investigación conjuntos
Leer la noticia

10/07/2025
La digitalización y la inteligencia artificial revolucionan el sector porcino
Leer la noticia

04/07/2025
Investigación con drones para una viticultura más sostenible
Leer la noticia

03/07/2025
Lleida se convierte en el epicentro del control sostenible de las malas hierbas que amenazan los cultivos
Leer la noticia

02/07/2025
Agrotecnio organiza una jornada de campo sobre roya negra en cereales en Teruel
Leer la noticia